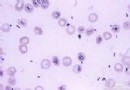

新生兒的三圍應該是多少?
新生兒的三圍應該是多少?
頭圍是反映頭部生長發育情況的重要指標。測量頭圍時應以卷尺取自眉弓上方最突出處經頭後面最凸起處(枕後隆起處)繞頭一周的長度。頭部的發育與體重、身高相似,年齡越小,發育越快。頭圍
頭圍是反映頭部生長發育情況的重要指標。測量頭圍時應以卷尺取自眉弓上方最突出處經頭後面最凸起處(枕後隆起處)繞頭一周的長度。頭部的發育與體重、身高相似,年齡越小,發育越快。出生時頭圍約34厘米,前半年增長較快,約8~10厘米,後半年約增加3厘米。到1歲時頭圍一般46厘米,2歲時48厘米,5歲時可達50厘米,15歲時可基本接近成人水平,平均54~58厘米。頭圍可反映腦和顱骨的發育程度,頭圍過小見於大腦發育不全及頭小畸形。而頭圍過大則見於腦積水。
胸圍
新生兒的胸部呈圓筒狀,前後徑與橫徑相差無幾,隨著年齡的增長,橫徑增長較快,前後徑增長較慢,逐漸形成成人的胸部。胸圍是反映肺、胸廓骨骼、肌肉和皮下脂肪發育程度的重要指標。測量胸圍時以卷尺沿乳頭下緣水平繞胸一周。出生時胸圍比頭圍小1~2厘米,平均為32.4厘米,1歲以後胸圍超過頭圍,肥胖小兒由於胸部皮下脂肪厚,在生後3~4個月時其胸圍可超過頭圍。營養不良、佝偻病患兒其胸圍超過頭圍的時間可推遲到1歲半以後。
有些疾病可引起胸部畸形,如佝偻病可形成雞胸或漏斗形,有些嚴重的先天性心髒病可使左側胸骨隆起。
腹圍
新生兒期由於腸管相對較長,且腹壁肌肉薄弱,腹部常較飽滿,以後逐漸變平。醫務人員常根據腹圍來衡量腹部發育情況。但腹圍測量數值易受各種因素的影響,正常范圍伸縮性很大,因此一般不測量腹圍。患腹部疾病如腹水、巨結腸時應及時測量。測量時以卷尺取平臍水平繞腹一周。2歲前腹圍與胸圍相等,2歲後則腹圍小於胸圍。
腹部皮下脂肪厚度是衡量兒童營養狀況的常用指標。測量方法為在腹部臍旁乳頭線上以拇指和食指相距3厘米處,將皮膚捏起,測量其上沿厚度。正常小兒多在0.8.厘米以上,如果低於0.8厘米則說明有不同程度的營養不良。
- 上一頁:新生兒前囟門摸了就啞了嗎
- 下一頁:新生兒應采取什麼睡眠姿勢
- 關於新生兒
-
被螨蟲咬傷應該怎麼治療
被螨蟲咬傷應該怎麼治療
-
喝水太多是病嗎
喝水太多是病嗎
-
新生兒1個月,懷疑舌臍帶是否短,在寶安看
新生兒1個月,懷疑舌臍帶是否短,在寶安看新生兒1個月
-
寶寶大量吐奶時應該如何應對
很多寶寶在喝奶的時候總是吐奶,讓新媽媽無所適從。在寶